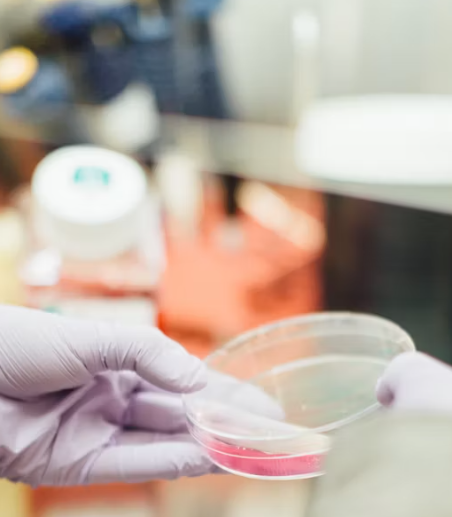

테토에겐테스트, 요즘 MZ세대가 열광하는 심리 유형 분석법
테토에겐테스트로 나의 감정 표현 방식과 연애 스타일을 알아보세요. 나와 어울리는 유형까지 분석해드립니다.
빠르게 테토에겐테스트 결과를 원하시면 아래에서 확인하세요.
요즘 SNS에서 핫하게 떠오르고 있는 테토에겐테스트, 혹시 들어보셨나요?
MBTI에 이어 MZ세대 사이에서 엄청난 인기를 끌고 있는 심리 유형 테스트로, 감정 표현 방식부터 연애 스타일, 관계 성향까지 분석해줘서 화제가 되고 있어요.
테토에겐테스트란?
테토에겐테스트는 ‘에겐’(에스트로겐 기반 감성형)과 ‘테토’(테스토스테론 기반 이성형)이라는 두 가지 성향을 바탕으로, 남성과 여성 각각의 특징을 조합해 4가지 유형으로 나눠주는 심리 테스트예요.
테스트 방식도 간단해요. 성별과 닉네임만 입력하면 약 20문항의 문답을 통해 자신의 성향을 빠르게 확인할 수 있습니다.
예를 들어, 감정을 자주 표현하는 사람이라면 ‘에겐’ 성향일 확률이 높고, 논리적으로 정리하고 표현하는 사람은 ‘테토’ 성향일 수 있어요. 이처럼 테토에겐테스트는 아주 일상적인 질문을 통해 자연스럽게 자신의 성향을 분석해줍니다.

유형별 특징은?
- 에겐녀: 감성적이고 공감을 잘하는 스타일. 감정을 소중히 여기고, 연애에선 배려심 깊은 파트너가 돼요.
- 테토남: 주도적이며 명확한 표현을 선호하는 스타일. 연애에서도 선을 긋고 정확한 관계 정의를 중요하게 생각하죠.
- 에겐남: 다정다감하고 로맨틱한 연애를 선호하는 스타일이에요. 감성 터지는 고백이나 이벤트를 좋아해요.
- 테토녀: 독립적이고 자기 주장이 확실한 스타일. 연애에서 감정보다는 행동과 태도를 더 중요하게 여깁니다.
이러한 유형 구분은 단순히 성별이나 성격을 나누는 게 아니라, 테토에겐테스트가 실제 연애 스타일이나 커뮤니케이션 방식에도 많은 통찰을 줄 수 있게 해줘요.

연애 궁합도 분석해줘요!
테토에겐테스트가 특별한 이유 중 하나는 바로 연애 궁합까지 보여준다는 점입니다.
예를 들어, 에겐녀와 테토남이 만나면 감성과 논리의 조화로 안정적인 관계를 만들 수 있고, 에겐남과 테토녀의 조합은 서로의 다른 스타일이 매력으로 작용하는 등 각 유형 간의 궁합 분석이 굉장히 흥미롭습니다.
테토에겐테스트를 친구들과 함께 해보면 “그래서 너는 왜 테토남만 좋아하냐” 같은 웃픈 대화들이 펼쳐지기도 해요. 단순한 테스트를 넘어, 서로의 이해를 도울 수 있는 좋은 대화 소재가 되어줍니다.



왜 이렇게 인기가 많을까?
MBTI가 익숙해진 요즘, 새로운 심리 테스트에 대한 호기심이 생기기 마련이죠.
테토에겐테스트는 ‘감정 표현’과 ‘소통 방식’을 중심으로 분석하기 때문에 실생활에서 유용하게 활용할 수 있는 장점이 많아요.
특히 연애나 인간관계에서 발생할 수 있는 갈등 원인을 유형별로 보여주기 때문에, 상대방의 스타일을 이해하고 갈등을 줄이는 데 도움을 줍니다.
저도 이 테스트 덕분에 “내가 표현을 잘한다고 생각했는데, 오히려 오해가 생길 수도 있었구나”라는 걸 깨닫고, 말하는 방식을 조금씩 바꿔가고 있어요.

실생활 적용 사례도 많아요
한 친구는 테토에겐테스트를 하고 나서 연인과의 싸움이 줄었다고 해요.
서로의 유형을 공유하면서 “나는 감정을 바로 말하는 게 편한데, 넌 생각 정리 후 말하길 좋아하는구나”라는 걸 알게 된 거죠.
이처럼 테토에겐테스트는 자기 이해는 물론, 타인에 대한 이해도 넓혀주는 심리 도구예요.
SNS에서 빠르게 퍼지고 있는 것도 이처럼 실제 관계에 도움이 된다는 점에서 공감받고 있는 거죠.
마무리
정리해볼게요!
- 테토에겐테스트는 감성과 이성의 균형을 기반으로 한 신개념 심리 테스트
- 총 4가지 유형(에겐남/테토남/에겐녀/테토녀)으로 분류
- 테스트 후 연애 성향 및 궁합까지 분석 가능
- 실제 인간관계에 적용 가능한 인사이트 제공
단순히 재미로 끝나는 테스트가 아니라, 나 자신을 더 잘 이해하고, 주변 사람들과의 관계를 개선하는 데도 효과적인 심리 툴인 만큼, 꼭 한 번 해보시길 추천드려요!
그리고 잊지 마세요. 지금 바로 테토에겐테스트 하러 가보는 거!
친구들과 유형 공유하면 더 재미있답니다. 😊

벽걸이 에어컨 물떨어짐 원인 셀프 해결법 총정리 📌
벽걸이 에어컨에서 갑자기 ‘뚝뚝’ 떨어지는 물방울, 여름철만 되면 반복되는 이 난감한 상황. 혹시 에어컨 고장일까 걱정되셨다면 지금부터 소개할 정보에 주목하세요. 🔽대부분은 간단한
6.tjswkdjaak.com
삼성 에어컨 Q9000 쾌적모드 에너지절약 하는법 📌
무더위가 시작되는 이 시기, 에어컨 선택은 단순한 구매를 넘어 '삶의 질'을 좌우합니다. 특히 삼성 Q9000처럼 똑똑한 쾌적모드를 갖춘 제품이라면 더욱 주목할 필요가 있죠. 🔽지금부터 단순 냉
6.tjswkdjaak.com
'알아두면 쓸모있는 정보' 카테고리의 다른 글
| 조정대상지역 지정현황 ( 40곳 서울 확인방법 경기도 부동산 규제지역 투기과열지구 지정현황) (0) | 2025.10.27 |
|---|---|
| 신호위반 범칙금 조회방법 📌 (0) | 2025.08.24 |
| 비지트 재팬 웹 작성방법 📌 (0) | 2025.08.20 |
| 카카오택시 사용법 바로가기 📌 (0) | 2025.08.17 |
| 벽걸이 에어컨 물떨어짐 원인 셀프 해결법 총정리 📌 (0) | 2025.06.30 |
| 노이즈 결말 해석 층간소음이 만든 진짜 공포 📌 (0) | 2025.06.30 |
| 머스트잇 개인정보 유출 보상받는법 📌 (0) | 2025.06.30 |
| 겜스고 유튜브 프리미엄 등록방법 (0) | 2025.06.30 |
댓글